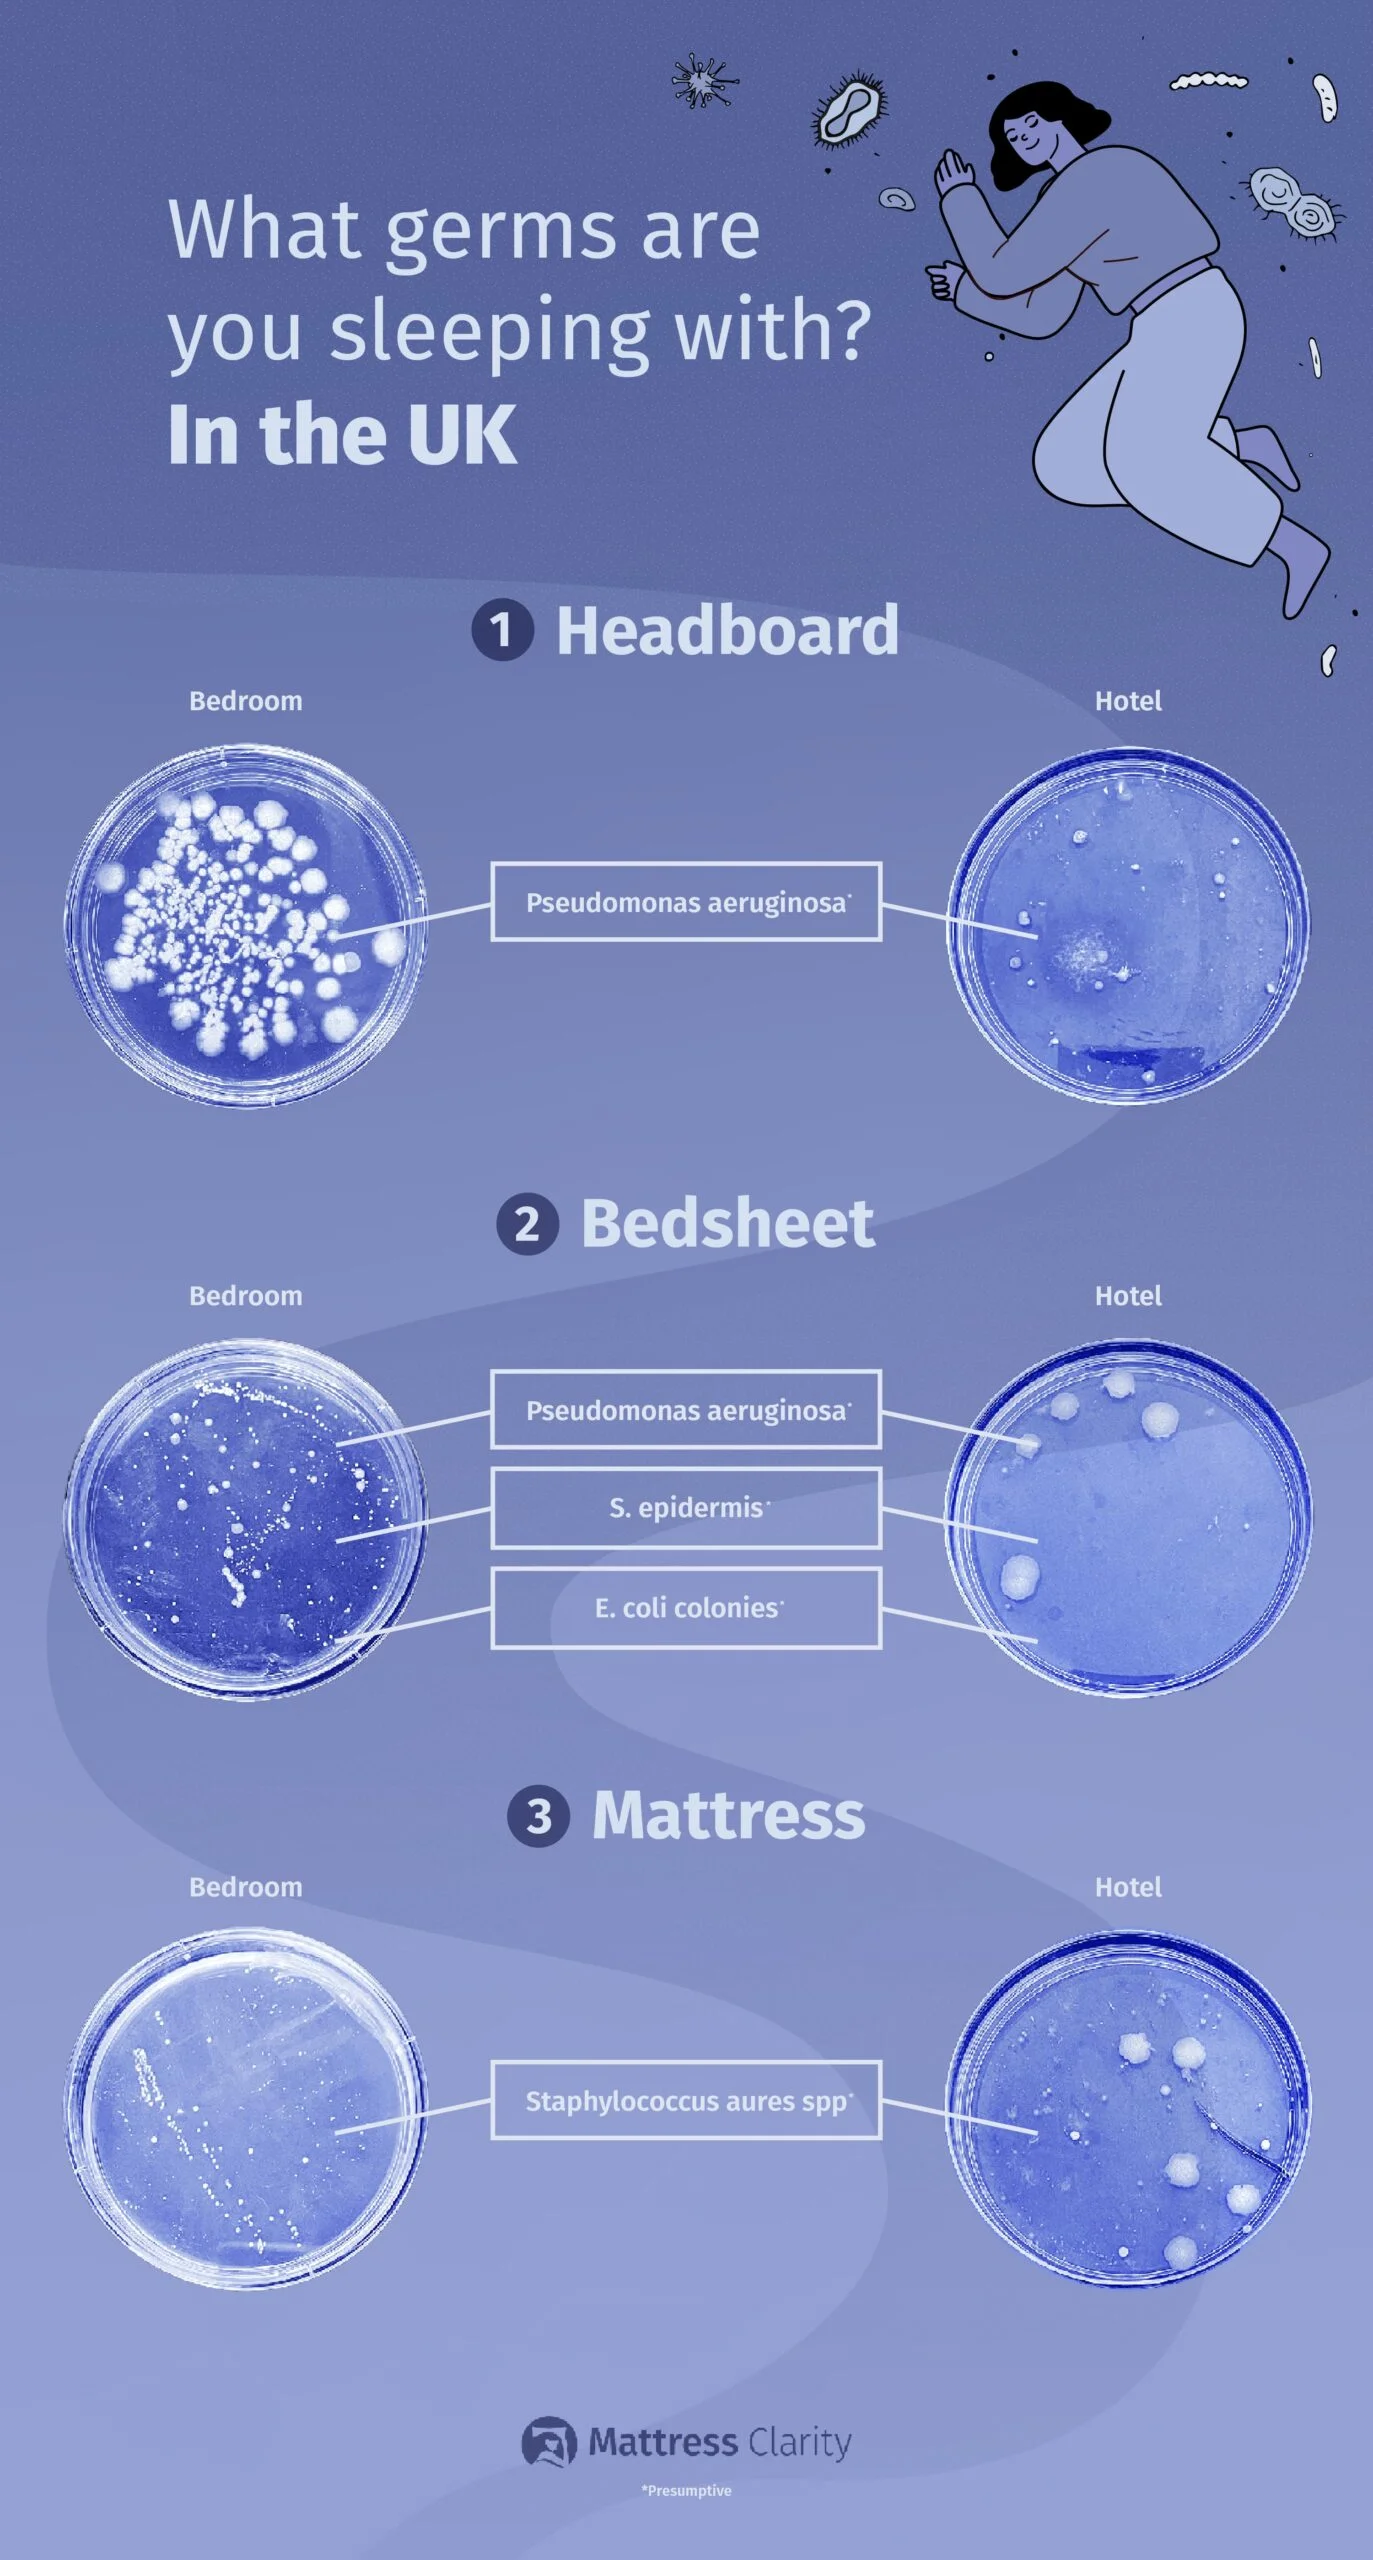
Image showing Petri dishes with bacteria on them that shows how dirty the UK sleeping spaces are.

When you think of getting into bed after a long day, you envision clean sheets, soft bedding, and a comfy mattress. You probably donโt consider that you might be snuggling into bed with some pretty gruesome bacteria!
We have undertaken a swab experiment to discover what bacteria is really lurking in your bedroom โ as well as tips on how you can tackle these pesky hidden germs.
Sleeping in a dirty environment can be detrimental to your health. Our lead reviewer Marten Carlson states โWhen you sleep in a dirty environment, it can make it more difficult to breathe at night, and this can negatively affect your sleep. Also, you may start to deal with allergies or even skin conditions.โ With the risk of an unclean bedroom impacting your sleep, itโs key to make sure your bedroom bacteria is at bay.
We have partnered with microbiologist Amy-May Pointer to analyze what bacteria is in your bed and what this really means for you.
What Germs are the U.S. Sleeping With?
We had a look at what germs Americans are harboring in their homes โ the results are pretty shocking!

Headboard
The worst offender for bedroom bacteria in the U.S. was revealed to be the headboard. Our microbiologist identified that this area contained a diverse species of fungus, mold colonies as well as bacterial colonies such as Staphylococcus aureus spp. that can lead to skin infections.
Our microbiologist explained that a headboard is often neglected during cleaning routines, so thereโs no surprise this is the worst contender for hosting microorganisms in your sleeping space.
Next time you wash your bed sheets, make sure to wipe down your headboard to help kill any harmful hidden bacteria.
Bedsheets
When looking at the nationโs bedsheets, bacteria such as Staphylococcus aureus spp. has been detected. This bacteria is renowned for living within bedding and can lead to skin infections โ if you have cuts on your skin this bacteria is one to be cautious around. It is also important to note the particular concern with this organism is that it can be antibiotic-resistant so treatment for those impacted by this bacteria could prove more difficult.
Mattress
Analyzing swabs of mattresses revealed mold and fungus to be a big problem for beds in the U.S. This is primarily from the humidity of the room where the mattress is stored, as mold thrives in a warm, humid, dark environment.
Microbiologist Amy-May Pointer recommends that you should air out your room with cool air and fold back your sheets to expose the mattress regularly as mold hates the light.
Molds can cause a range of issues including itchy skin rashes, asthma issues, and breathing difficulties so itโs important to stay on top of mold-related problems.
Our microbiologist also recommends making sure to wear your pajamas to avoid sweating directly onto your bed, as this may be causing damp sheets and bedding that could also contribute to mold growth.
Where in the U.S. Needs Help With Cleaning Their Bedroom?
We have looked at Google search data to uncover what U.S. states are looking for when it comes to cleaning their mattress and keeping their sleep space clean.

The U.S. city most in search of advice on how to clean their sleep space is California, with the state searching for mattress cleaning advice over 34,000 times a year.
Texas takes the second spot, with 28,800 searches per year and, coming in joint 3rd place, is New York and Florida with 19,200 searches a year looking for the term โhow to clean a mattressโ.
What Germs are the U.K. Sleeping With?
Headboard
How does the U.K. compare? The swab experiment revealed that the dirtiest area across the pond was also the headboard.
When looking at what might be lurking on U.K. headboards it was found that the main bacteria is likely to be Pseudomonas aeruginosa spp., a bacteria that can cause infection including deep rashes and abscesses, especially in those with weakened immune systems.
Bedsheets
The second dirtiest area was found to be the bedsheets. It was almost as bad as the headboard and contained the same organism (Pseudomonas aeruginosa spp.). The sheets also hosted S. epidermidis spp., which can cause acne.
Escherichia coli (A.k.a. E Coli) was also found on the sheets, which would most likely come from stool or urine. Marten Carlson has some top tips for cleaning urine from your bedding later on in this article!
The sheets also homed Pseudomonas aeruginosa, which can cause a range of infections and can be more serious, but this is very rare.
Mattress
The cleanest of the tested items was found to be the mattress, however, that doesnโt mean itโs without any bacteria. The mattress was found to have Staphylococcus aureus, a common bacteria found often in bedding, surfaces, and on our own skin.
Our microbiologist states that, although not often, it can lead to skin infections and it is essential for those with compromised skin-cuts, for example, to be careful with this organism. It is imperative to wash down mattresses regularly as these can harbor tons of skin cells and bacteria and fungus can thrive here, eventually becoming harmful in high numbers and to immunocompromised people especially.
U.K. vs U.S. โ What are the Dirtiest Areas of your Sleep Space?

When it comes to your sleep environment, be it at home or in a hotel, it can be hard to pinpoint the worst offending areas for dirt. We asked our microbiologist to look at how many microbes were found in beds across the U.S. and the U.K. to uncover the dirtiest and cleanest areas.
The cleanest area with the lowest levels of microbes is the mattress, across both the U.K. and the U.S. The levels of microbes detected on these were lower than in other areas of the bedroom โ perhaps due to items such as mattress protectors and bedsheets acting as a barrier of protection for mattresses.
When looking at the comparison of the U.K. and the U.S., the U.S. has been revealed to have dirtier bedrooms.
The most contaminated sample was that gathered from a U.S. bedroom, containing diverse species of fungus, mold colonies as well as bacterial colonies such as Staphylococcus aureus spp. that can cause some pretty painful skin infections.
Environmental conditions could explain this discrepancy; higher temperatures create an ideal environment โ moisture, heat, and darkness underneath bed sheets โ for fungal organisms to flourish, while sweat provided by those living within these climates provide further sustenance for growth.
Top Tips to Keep your Sleep Space Clean
We have asked our lead reviewer Marten Carlson to provide some top tips on how to keep your bedroom clean.
How to keep your space free from germs
- You first want to make sure that you change out and clean your sheets and other bedding on a regular basis. They are the first culprit when it comes to a dirty sleep space and an easy one to combat.
- Try using a mattress protector to help prevent stains.
- If you have a pet, letting them in the bed can make it much more difficult to keep your sleep space clean, and pet dander is a major cause of allergies.
- Finally, if you do make a mess on your mattress, clean it promptly.
RELATED: Best Air Purifying Plants for Your Bedroom
What signs of wear and tear should you look for on a mattress?
There are a few signs of wear and tear that might show up on a mattress. First off, there are cosmetic signs: stains, tears, or lumps in the mattress. There are other signs you may notice while you are sleeping, namely sagging in the mattress. You will note this in the slope of the mattress, and youโll also feel it in your body the next day in the form of aches and pains.
How should you clean your mattress? And how often?
You should vacuum your mattress every three to six months. If you are using a mattress protector, make sure to also clean that in the wash.
If your mattress has a stain, that is a different story. Fresh urine stains can be treated with a 50/50 mix of water and white vinegar. Use a spray bottle and apply the mixture to the stain and blot away excess liquid with a towel. Finally, sprinkle baking soda on the stain and let it rest for at least eight hours. For dry urine stains, mix hydrogen peroxide, baking soda, and liquid dish soap, and spray the mixture on the stain. Once the mattress has dried, vacuum up the residue and repeat until the stain is gone.
For sweat stains, mix hydrogen peroxide, liquid dish soap, and water. Spray the liquid mixture on the stain and let stand for 20 minutes. Blot any extra liquid that you find. Then, sprinkle baking soda on the stain and let it sit for at least 24 hours. Finally, vacuum the residual baking soda and repeat if necessary.
When to get a new mattress
There are a few signs you need a new mattress. First off, you may find lumps or sagging in the mattress. If your mattress starts to smell or you are struggling with allergies after waking up, your mattress may be harboring bacteria, germs, and allergens. Finally, if youโre waking up with aches and pains, specifically in your back, itโs time for a new mattress. Your current mattress isnโt giving you the support you require, and this can take a toll on your joints and back.
How regularly should you change your mattress?
We recommend that you switch out your mattress every 7-10 years. That being said, some lower-end mattresses may need to be replaced within just a few years.
Methodology
In order to undertake this experiment we got down and dirty swabbing our bedrooms. We swab-tested three key areas, including mattresses, headboards, and bed linen in the U.S. and the U.K. After the initial swabs developed, they were sent to a microbiologist who provided an analysis of what the bacteria presented could be. When looking at the hotel swabs the same process was undertaken. Hotels used as part of the experiment will remain anonymous.
All microbiologist analysis is presumptive as swabs have not been investigated within a lab environment.
For search volume data, we used Google KWP to uncover the search volume by state for the term โHow to clean a mattressโ to reveal where in the U.S. is searching for this most frequently over the course of a year.
All data correct as of December 2022.

